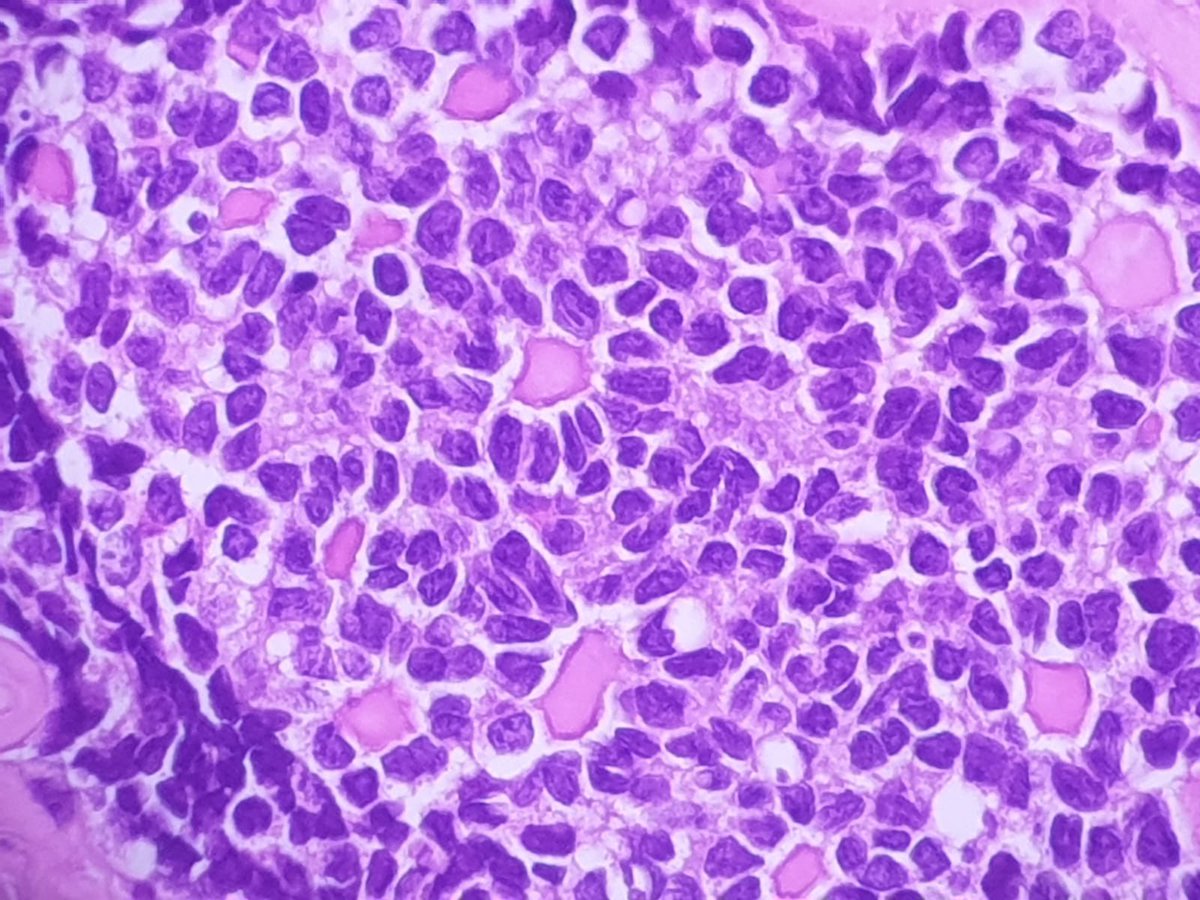
Incidental tiny nodule (less than 0,5 mm) in the wall of an endometriosis cyst in a pregnant woman #gynpath #pathtwitter

Granulosa cell proliferation of pregnancy?

Fresia
@fresia_jw
Pathologist. Mom of two.
ID: 473667825
25-01-2012 06:33:45
415 Tweet
257 Takipçi
368 Takip Edilen




Day 1 of the Philippine Society of Pathologists 2025 updates in surgical pathology. #GynPath session by Joe Rabban. It’s such a pleasure to see you again!


#gynpath #placentalpath #breastpath 🤎🤎 Pathology Update 2025. Thank you The Royal College of Pathologists of Australasia #pathTwitter










Y-GTD case of August 2025: files-profile.medicine.yale.edu/documents/5739… Yale Pathology bit.ly/48Yq1pO

Happy Monday everyone! Time for our Breast Consult Case of the Week 3 #BCCW. This is a 65-year-old woman with an 8 mm breast mass. The last image is an immunohistochemical stain for p63. What is your diagnosis? #breastpath #PathTwitter WashU Medicine Pathology & Immunology Education WashU Medicine Pathology & Immunology


Sunday well spent 🌼🌸 San Francisco Botanical Garden #flowerpiano 🎹